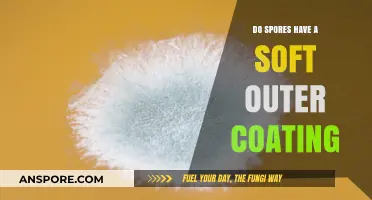
Exploring the Soft Outer Coating of Spores: Fact or Fiction?

The question of whether spores contaminate mushroom grows is a critical concern for cultivators, as contamination can significantly impact yield and quality. Spores, being the reproductive units of fungi, are naturally present in the environment and can inadvertently introduce unwanted microorganisms or competing molds into the growing substrate. While spores themselves are not inherently contaminants, their presence in uncontrolled conditions can lead to the proliferation of harmful bacteria, yeasts, or other fungi, which compete with the desired mushroom mycelium for nutrients. Proper sterilization techniques, such as pasteurization or autoclaving, are essential to minimize spore-related contamination, ensuring a healthy and successful mushroom cultivation process. Understanding the role of spores and implementing preventive measures is key to maintaining a clean and productive grow environment.
| Characteristics | Values |
|---|---|
| Spores as Contaminants | Spores from various fungi, including molds and bacteria, can contaminate mushroom grows. Common contaminants include Trichoderma, Aspergillus, and Penicillium. |
| Sources of Contamination | Spores can enter grows via air, water, substrate, tools, or unsterilized equipment. Poor hygiene practices and inadequate sterilization increase risk. |
| Impact on Mushroom Grow | Contaminants compete for nutrients, reduce yield, and may produce toxins harmful to mushrooms or humans. Severe cases can lead to crop failure. |
| Prevention Methods | Sterilize substrate and equipment, maintain clean environment, use HEPA filters, and practice proper hygiene. Avoid introducing foreign materials. |
| Detection | Early signs include discoloration, unusual growths, or off-odors. Microscopic examination or lab testing can confirm contamination. |
| Common Contaminants | Trichoderma (green mold), Aspergillus (black or green mold), Penicillium (blue or green mold), and bacterial slime. |
| Spores Viability | Spores can remain dormant for long periods and survive harsh conditions, making them difficult to eradicate once introduced. |
| Remediation | Affected areas should be removed and disposed of. Re-sterilize the environment and restart the grow if contamination is widespread. |
| Risk Factors | High humidity, poor ventilation, and unsterilized substrates increase contamination risk. Outdoor grows are more susceptible due to exposure. |
| Best Practices | Use sterile techniques, monitor grow conditions, and isolate contaminated areas promptly to prevent spread. |
Explore related products
What You'll Learn

Spores' Role in Contamination
Spores, the microscopic reproductive units of fungi, are ubiquitous in the environment, floating through the air and settling on surfaces with every breath and breeze. In the context of growing mushrooms, their role in contamination is both critical and paradoxical. While spores are essential for mushroom cultivation, their omnipresence makes them a double-edged sword. A single spore from an unwanted fungus can hijack your grow, outcompeting your desired species and ruining your harvest. Understanding this duality is the first step in managing contamination effectively.
Consider the process of inoculation: you intentionally introduce spores of your chosen mushroom species into a sterile substrate. This controlled environment is designed to favor the growth of your selected fungus. However, if competing spores infiltrate the substrate—whether from unsterilized tools, contaminated air, or improper handling—they can quickly take over. For instance, molds like *Trichoderma* or *Aspergillus* thrive in the same conditions as mushrooms and can colonize faster, leaving your desired mycelium struggling for resources. The key takeaway here is that while spores are the foundation of your grow, they are also the primary vectors of contamination.
To mitigate spore-induced contamination, adopt a multi-pronged approach. First, sterilize all equipment and substrates thoroughly; autoclaving at 121°C (250°F) for 30 minutes is industry standard. Second, work in a clean environment, ideally a still-air box or laminar flow hood, to minimize airborne spores. Third, practice good hygiene: wear gloves, a mask, and a lab coat to reduce the risk of introducing spores from your skin, hair, or clothing. Finally, monitor your grow closely; early detection of contaminants allows for swift intervention, such as removing affected areas or increasing air circulation to discourage mold growth.
Comparing spore contamination to a game of chess highlights the strategic nature of prevention. Just as a single misstep can cost you the game, a single spore can derail your grow. Proactive measures, like using spore syringes from reputable suppliers and testing new substrates before full-scale use, act as your opening moves, setting the stage for success. Reactive strategies, such as isolating contaminated grows and improving environmental controls, are your mid-game tactics, adapting to challenges as they arise. By mastering both, you can tip the balance in favor of your desired mushrooms.
In practice, think of spores as both your allies and adversaries. Their resilience and adaptability make them powerful tools for cultivation, but these same traits enable contamination. For example, a home grower might notice green mold (*Trichoderma*) spreading across their substrate within days of a failed sterilization attempt. This scenario underscores the importance of precision and consistency in every step of the process. By treating spores with respect—acknowledging their potential for both creation and destruction—you can harness their power while minimizing their risks.
Understanding Isolated Spore Syringes: A Beginner's Guide to Mushroom Cultivation
You may want to see also

Preventing Contamination in Grow Rooms
Spores are a common concern in grow rooms, as they can quickly contaminate crops and lead to significant losses. To prevent this, it’s essential to understand that spores thrive in environments with high humidity, organic matter, and stagnant air. Implementing a multi-faceted approach is key to maintaining a sterile growing environment. Start by controlling humidity levels; aim for 40-60% relative humidity during vegetative growth and reduce it to 40-50% during flowering to discourage spore germination. Use dehumidifiers and ensure proper ventilation to maintain airflow, as spores settle more easily in still air.
A critical step in preventing contamination is maintaining impeccable hygiene. All tools, surfaces, and equipment should be sterilized regularly using a 10% bleach solution or 70% isopropyl alcohol. For example, before entering the grow room, require all personnel to wear sterile gloves, shoe covers, and lab coats. Additionally, install HEPA filters in your HVAC system to capture airborne spores, which can be as small as 1-10 micrometers. Regularly replace filters to ensure their effectiveness, as clogged filters can become breeding grounds for contaminants.
Another effective strategy is to use beneficial microorganisms to outcompete harmful spores. Introduce *Bacillus subtilis* or *Trichoderma* species, which are known to suppress fungal pathogens. These biocontrol agents can be applied as soil amendments or foliar sprays at a rate of 1-2 ounces per gallon of water. However, ensure compatibility with your crops, as some strains may affect plant growth. Monitor the grow room’s microbial population weekly using agar plates to detect early signs of contamination and adjust your strategy accordingly.
Comparing traditional methods to modern technology, UV-C sterilization systems offer a cutting-edge solution. These systems emit ultraviolet light at 254 nanometers, effectively killing spores and other pathogens without chemicals. Install UV-C lamps in ductwork or as standalone units, ensuring they operate during off-hours to avoid human exposure. While the initial cost is higher, the long-term savings in crop losses and chemical expenses make it a worthwhile investment. Pair this with a rigorous cleaning schedule for optimal results.
Finally, adopt a proactive mindset by quarantining new plants and materials before introducing them to the grow room. Inspect all incoming items for visible mold or discoloration, and isolate them for at least 72 hours. During this period, treat them with a fungicide or biocontrol agent to eliminate potential spores. Educate your team on contamination risks and enforce strict protocols, as human error is often the weakest link in prevention efforts. By combining these strategies, you can create a robust defense against spore contamination and safeguard your grow room’s productivity.
Should You Download All Spore DLC? A Comprehensive Guide
You may want to see also

Common Contaminants from Spores
Spores, often invisible to the naked eye, are a significant concern for mushroom cultivators due to their ability to introduce contaminants that can ruin an entire grow. These microscopic entities, primarily from bacteria, molds, and other fungi, thrive in the same conditions that mushrooms require—moisture, organic matter, and warmth. Understanding the common contaminants derived from spores is crucial for implementing effective preventive measures.
Bacterial Contaminants: A Stealthy Threat
Bacteria, such as *Bacillus* and *Pseudomonas*, are among the most common spore-derived contaminants in mushroom grows. These bacteria form resilient endospores that can survive harsh conditions, including pasteurization and sterilization processes. Once introduced, they compete with mycelium for nutrients, often leading to slimy, discolored patches on substrates. To combat this, cultivators should maintain sterile techniques, such as using autoclaves to sterilize substrates at 121°C for 30–60 minutes, and avoid overwatering to reduce bacterial proliferation.
Mold Spores: The Visible Invader
Molds, including *Trichoderma* and *Aspergillus*, are fungal contaminants that produce spores easily dispersed through air or contact. These molds grow rapidly, forming green, black, or white patches that outcompete mushroom mycelium. Unlike bacteria, molds are eukaryotic and more closely related to mushrooms, making them harder to eradicate. Preventive measures include HEPA filters to reduce airborne spores, regular sanitization of grow rooms with 70% isopropyl alcohol, and the use of competitive fungi like *Trichoderma* antagonists in controlled environments.
Yeast Contaminants: The Overlooked Saboteur
Yeasts, such as *Candida* and *Saccharomyces*, are often overlooked but can be devastating to mushroom grows. These single-celled fungi produce spores that survive in dormant states until conditions are favorable. Yeast contamination manifests as a frothy, bubbly appearance on the substrate surface, depleting nutrients and producing inhibitory compounds. To mitigate yeast, cultivators should use distilled water, avoid sugary additives in substrates, and monitor pH levels (aim for 5.5–6.5) to create an unfavorable environment for yeast growth.
Practical Tips for Prevention
Prevention is key when dealing with spore-derived contaminants. Start by sourcing clean, high-quality spawn and substrates. Implement a strict hygiene protocol, including wearing gloves, masks, and lab coats during handling. Use spore traps and air purifiers to minimize airborne contamination. For small-scale growers, pressure cooking substrates at 15 psi for 90 minutes ensures sterilization. Regularly inspect grows for early signs of contamination, such as unusual colors or textures, and isolate affected areas immediately to prevent spread.
While spores are omnipresent, their impact on mushroom grows can be minimized through informed practices. By understanding the specific threats posed by bacterial, mold, and yeast contaminants, cultivators can tailor their strategies to protect their crops. Consistent sterilization, environmental control, and proactive monitoring are not just recommendations—they are essential habits for successful mushroom cultivation.
Using Spore on Cradily: Strategies and Effectiveness in Pokémon Battles
You may want to see also
Explore related products
$17.51 $19.99

Sterilization Techniques for Grow Spaces
Spores are everywhere, and their resilience makes them a significant threat to mushroom cultivation. A single contaminant spore can derail an entire grow, making sterilization not just beneficial but essential. Here’s how to create a spore-free environment for your mushrooms.
Pressure Cooking: The Gold Standard
The autoclave, or pressure cooker, is the most reliable method for sterilizing substrates and tools. By heating contents to 121°C (250°F) under 15 PSI for 30–90 minutes, it eliminates spores, bacteria, and fungi. This technique is ideal for bulk substrates like grain or manure. Always follow safety protocols: ensure proper sealing, use a release valve, and allow cooling before handling. For smaller batches, a 60-minute cycle suffices, while denser materials may require up to 90 minutes.
Chemical Sterilization: A Quick Alternative
When pressure cooking isn’t feasible, chemical agents like hydrogen peroxide (3–6% solution) or bleach (1:9 bleach-to-water ratio) offer a fast fix. Wipe down surfaces, tools, and containers, letting them air dry to avoid residue. Hydrogen peroxide decomposes into water and oxygen, making it safer for organic grows. However, chemicals are less effective on porous materials and may not penetrate deeply enough to kill all spores. Use sparingly and ventilate the area to prevent inhalation risks.
Flaming and Heat Treatment: Precision Sterilization
For small tools like scalpels or inoculation loops, direct flame sterilization is both quick and effective. Pass the metal portion through a bunsen burner flame until it glows red, ensuring all surfaces are exposed. This method is unsuitable for plastics or heat-sensitive materials. Alternatively, dry heat sterilization in an oven at 170°C (340°F) for 2 hours works for glassware or metal equipment. Always handle heated items with tongs to prevent burns.
Environmental Control: Preventing Re-Contamination
Sterilizing your grow space goes beyond tools and substrates. HEPA filters in laminar flow hoods capture airborne spores, while UV-C light (254 nm wavelength) can sterilize surfaces and air. Run UV-C for 15–30 minutes in unoccupied rooms, as prolonged exposure is harmful to humans. Maintain a clean-room protocol: wear gloves, masks, and sterile clothing, and limit access to the grow area. Regularly disinfect walls and floors with 70% isopropyl alcohol to break the contamination cycle.
By combining these techniques—pressure cooking for substrates, chemicals for surfaces, heat for tools, and environmental controls—you create a multi-layered defense against spore contamination. Consistency and attention to detail are key; one overlooked step can undo hours of preparation. Treat sterilization as a ritual, not a chore, and your mushroom grows will thrive uncontaminated.
Can Bacteria Reproduce in a Spore? Unveiling the Survival Mechanism
You may want to see also

Identifying Spores in Mushroom Cultures
Spores are the microscopic seeds of mushrooms, essential for propagation but often misunderstood in cultivation. Identifying them within a culture is crucial to distinguish between desired mushroom spores and contaminants. Under a microscope at 400x magnification, mushroom spores appear as distinct, pigmented ovals or ellipsoids, often with a smooth surface. Contaminants like bacteria or mold spores, in contrast, may appear smaller, irregular, or clumped together. This visual differentiation is the first step in ensuring a healthy grow.
To identify spores effectively, prepare a spore print or dilute a spore suspension on a glass slide. Use a sterile needle to extract a small sample from the culture, ensuring no cross-contamination. Add a drop of distilled water and a coverslip, then examine under the microscope. Look for uniformity in size and shape, as mushroom spores within the same species are remarkably consistent. For example, *Psilocybe cubensis* spores are typically 10-14 x 8-9 micrometers, with a dark purple-brown color. Deviations from these characteristics may indicate contamination.
Advanced cultivators can employ staining techniques to enhance identification. Methylene blue or cotton blue stains highlight spores and differentiate them from hyphae or bacterial cells. This method is particularly useful when dealing with light-colored spores or ambiguous samples. However, caution is necessary: over-staining can obscure details, and improper handling may introduce contaminants. Always work in a sterile environment, using flame-sterilized tools and a still air box if available.
Understanding spore behavior in a culture is equally important. Healthy spores germinate into hyphae, forming a mycelial network that appears as white, thread-like growth. Contaminants, such as trichoderma or bacteria, often manifest as discolored patches, slimy textures, or unusual odors. Regular monitoring of the culture’s appearance and growth rate helps detect issues early. For instance, if the mycelium turns green or smells foul, contamination is likely, and the culture should be discarded to prevent spread.
In conclusion, identifying spores in mushroom cultures requires a combination of microscopy skills, preparation techniques, and observational awareness. By mastering these methods, cultivators can ensure their grows remain free of contaminants, leading to healthier and more productive harvests. Remember, precision and sterility are key—a small oversight can compromise an entire culture.
Understanding Bacterial Spores: Formation, Function, and Survival Mechanisms
You may want to see also
Frequently asked questions
Yes, spores can introduce contaminants if they come from an unsterile source or if the growing environment is not properly sanitized.
Spores can carry bacteria, mold, or other microorganisms that thrive in the same conditions as mushrooms, leading to contamination if not controlled.
Yes, contaminated spores can spread quickly, infecting the substrate and mycelium, often resulting in a failed or compromised harvest.
Use sterile techniques, such as sterilizing equipment, working in a clean environment, and sourcing spores from reputable suppliers to minimize contamination risks.
No, some contaminants may not be immediately visible and can only be detected as the grow progresses, such as through slowed growth or unusual colors.